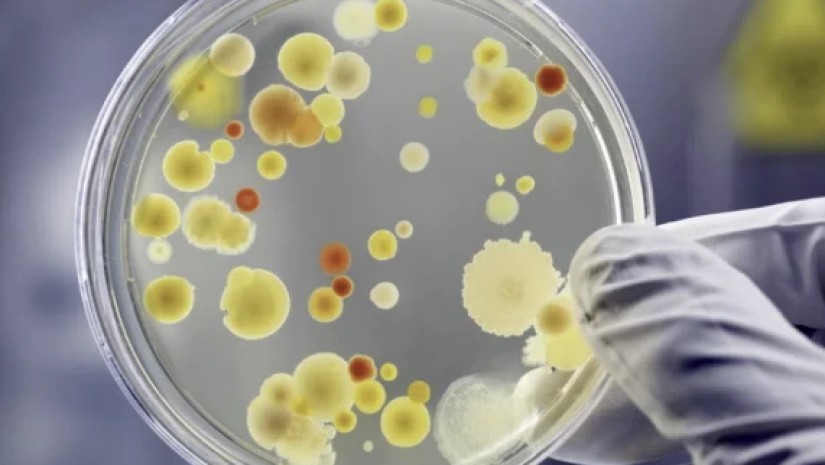

როგორ ამოვიცნოთ პარაზიტული ინფექციები ბავშვებში
ციციშვილის სახელობის ბავშვთა საავადმყოფოს კლინიკური დირექტორი, მაია ჩხაიძე, გადაცემაში “დილა მშვიდობისა საქართველო” საუბრობს, როგორ უნდა მიხვდეს მშობელი, რომ ბავშვს ჭიები ჰყავს
როგორ ამოვიცნოთ პარაზიტული ჭიები ბავშვებში – სიმპტომები, რისკები და პრევენცია
პატარებში პარაზიტული ინფექციები ხშირად რთულად შესამჩნევია, რადგან მათი სიმპტომები სხვა დაავადებებისას ჰგავს. სწორედ ამიტომ, ხშირად არც მშობელი და ზოგჯერ ვერც პედიატრი ვერ ხვდება, რომ ბავშვი ჭიებით არის დაინფიცირებული, სანამ მდგომარეობა არ გართულდება. გააგრძელეთ კითხვა
გადმოწერე აპლიკაცია „შენი ექიმი“ – პირველი ქართული სამედიცინო პლატფორმა!
მიიღე სანდო და აქტუალური ინფორმაცია ჯანმრთელობის შესახებ – საქართველოდან და მთელი მსოფლიოდან.
iPhone: https://apps.apple.com/fr/app/sheni/id6746877342?l=en-GB
Telegram არხი: https://t.me/SheniEkimi
შენი ექიმი – ცოდნა ჯანმრთელობისთვის.


